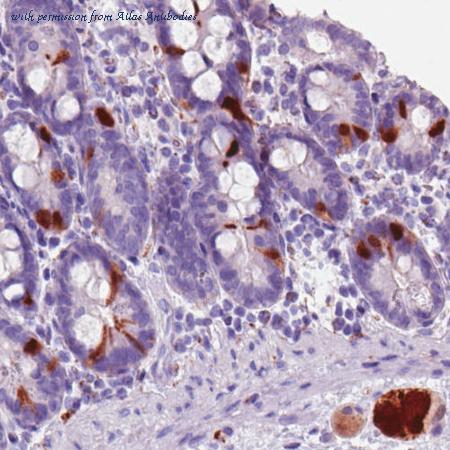
Atlas Antibodies AMAb90630 image 3

product summary
company name :
Atlas Antibodies
product type :
antibody
product name :
Anti-SCGN
catalog :
AMAb90630
quantity :
100 µl
clonality :
monoclonal
host :
mouse
conjugate :
nonconjugated
clone name :
reactivity :
human
application :
western blot, immunohistochemistry
more info or order :
citations: 1
image
image 1 :

Immunohistochemical staining of human pancreas shows strong cytoplasmic and nuclear immunoreactivity in the islets of Langerhans.
image 2 :

Immunohistochemical staining of human cerebellum shows moderate nuclear positivity in the molecular layer.
image 3 :
Immunohistochemical staining of human duodenum shows strong immunoreactivity in the neuroendocrine cells, as well as in the local ganglionic cells.
product information
product number :
AMAb90630
product name :
Anti-SCGN
clone number :
CL0271
ensembl gene id :
ENSG00000079689
gene description :
secretagogin, EF-hand calcium binding protein
alternative names :
CALBL, DJ501N12.8, SECRET, SEGN
supportive applications :
IHC, WB
clonality :
Monoclonal
category :
Primary
antigen type :
Recombinant Protein Epitope Signature Tag (PrEST) antigen sequence
antigen sequence :
RDLFLHHKKAISEAKLEEYTGTMMKIFDRNKDGRLDLND
LARILALQENFLLQFKMDACSTEERKRDFEKIFAYYDVS
KTGALEGPEVDGFVKDMMELVQPSISGVDLDKFREILLR
HCDVNKDGKIQKSELALCLGLK
LARILALQENFLLQFKMDACSTEERKRDFEKIFAYYDVS
KTGALEGPEVDGFVKDMMELVQPSISGVDLDKFREILLR
HCDVNKDGKIQKSELALCLGLK
epitope specificity :
Binds to an epitope located within the peptide sequence None as determined by overlapping synthetic peptides.
host animal :
Mouse
species reactivity :
Human
isotype :
IgG1
purification method :
Protein A purified
buffer :
40% glycerol and PBS (pH 7.2). 0.02% sodium azide is added as preservative.
storage :
Store at +4°C for short term storage. Long time storage is recommended at -20°C.
unit :
100 µl
uniprot id :
O76038
conjugate :
unconjugated
antigen sequence identity mouse :
96
antigen sequence identity rat :
96
more info or order :
company information
Atlas Antibodies
AlbaNova University Center
SE-106 91 Stockholm
SE-106 91 Stockholm
contact@atlasantibodies.com
www.atlasantibodies.com46 8 54 59 58 50
headquarters: Sweden
review
product type
browse more products
questions and comments
